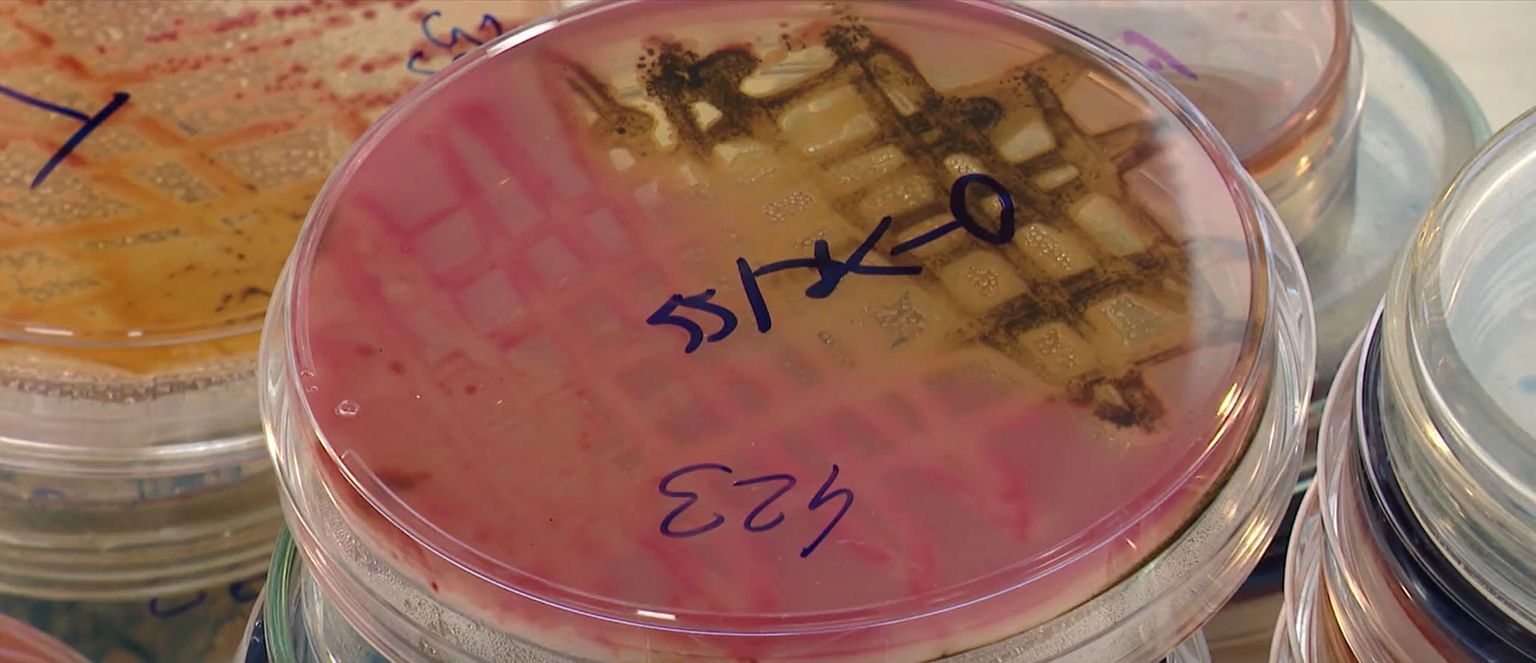

-
 Salmonela na Lošinju - 1 Foto: DNEVNIK.hr
Salmonela na Lošinju - 1 Foto: DNEVNIK.hr -
 Zoran Barušić, infektolog Foto: DNEVNIK.hr
Zoran Barušić, infektolog Foto: DNEVNIK.hr -
 Salmonela na Lošinju - 2 Foto: DNEVNIK.hr
Salmonela na Lošinju - 2 Foto: DNEVNIK.hr -
Salmonela na Lošinju - 3 Foto: DNEVNIK.hr
Salmonela na Lošinju - 3 Foto: DNEVNIK.hr -
 Salmonela na Lošinju - 4 Foto: DNEVNIK.hr
Salmonela na Lošinju - 4 Foto: DNEVNIK.hr -
Pogledaj i ovo



 +
2
+
2

Svjetski dan sigurnosti hrane
Opasnost zbog koje neki i nakon 20 godina imaju posljedice: "Čim je nagla promjena vremena, ovo vrišti. Oči bole, kidaju"




slučajevi salmonele
Deseci oboljelih diljem zemlje, a svima je zajedničko ljetovanje u istom hotelu: Stigle prve analize vode




Reagirao Državni inspektorat
Među djelatnicima hotela pronađene kliconoše salmonele: Naređene protuepidemijske mjere

